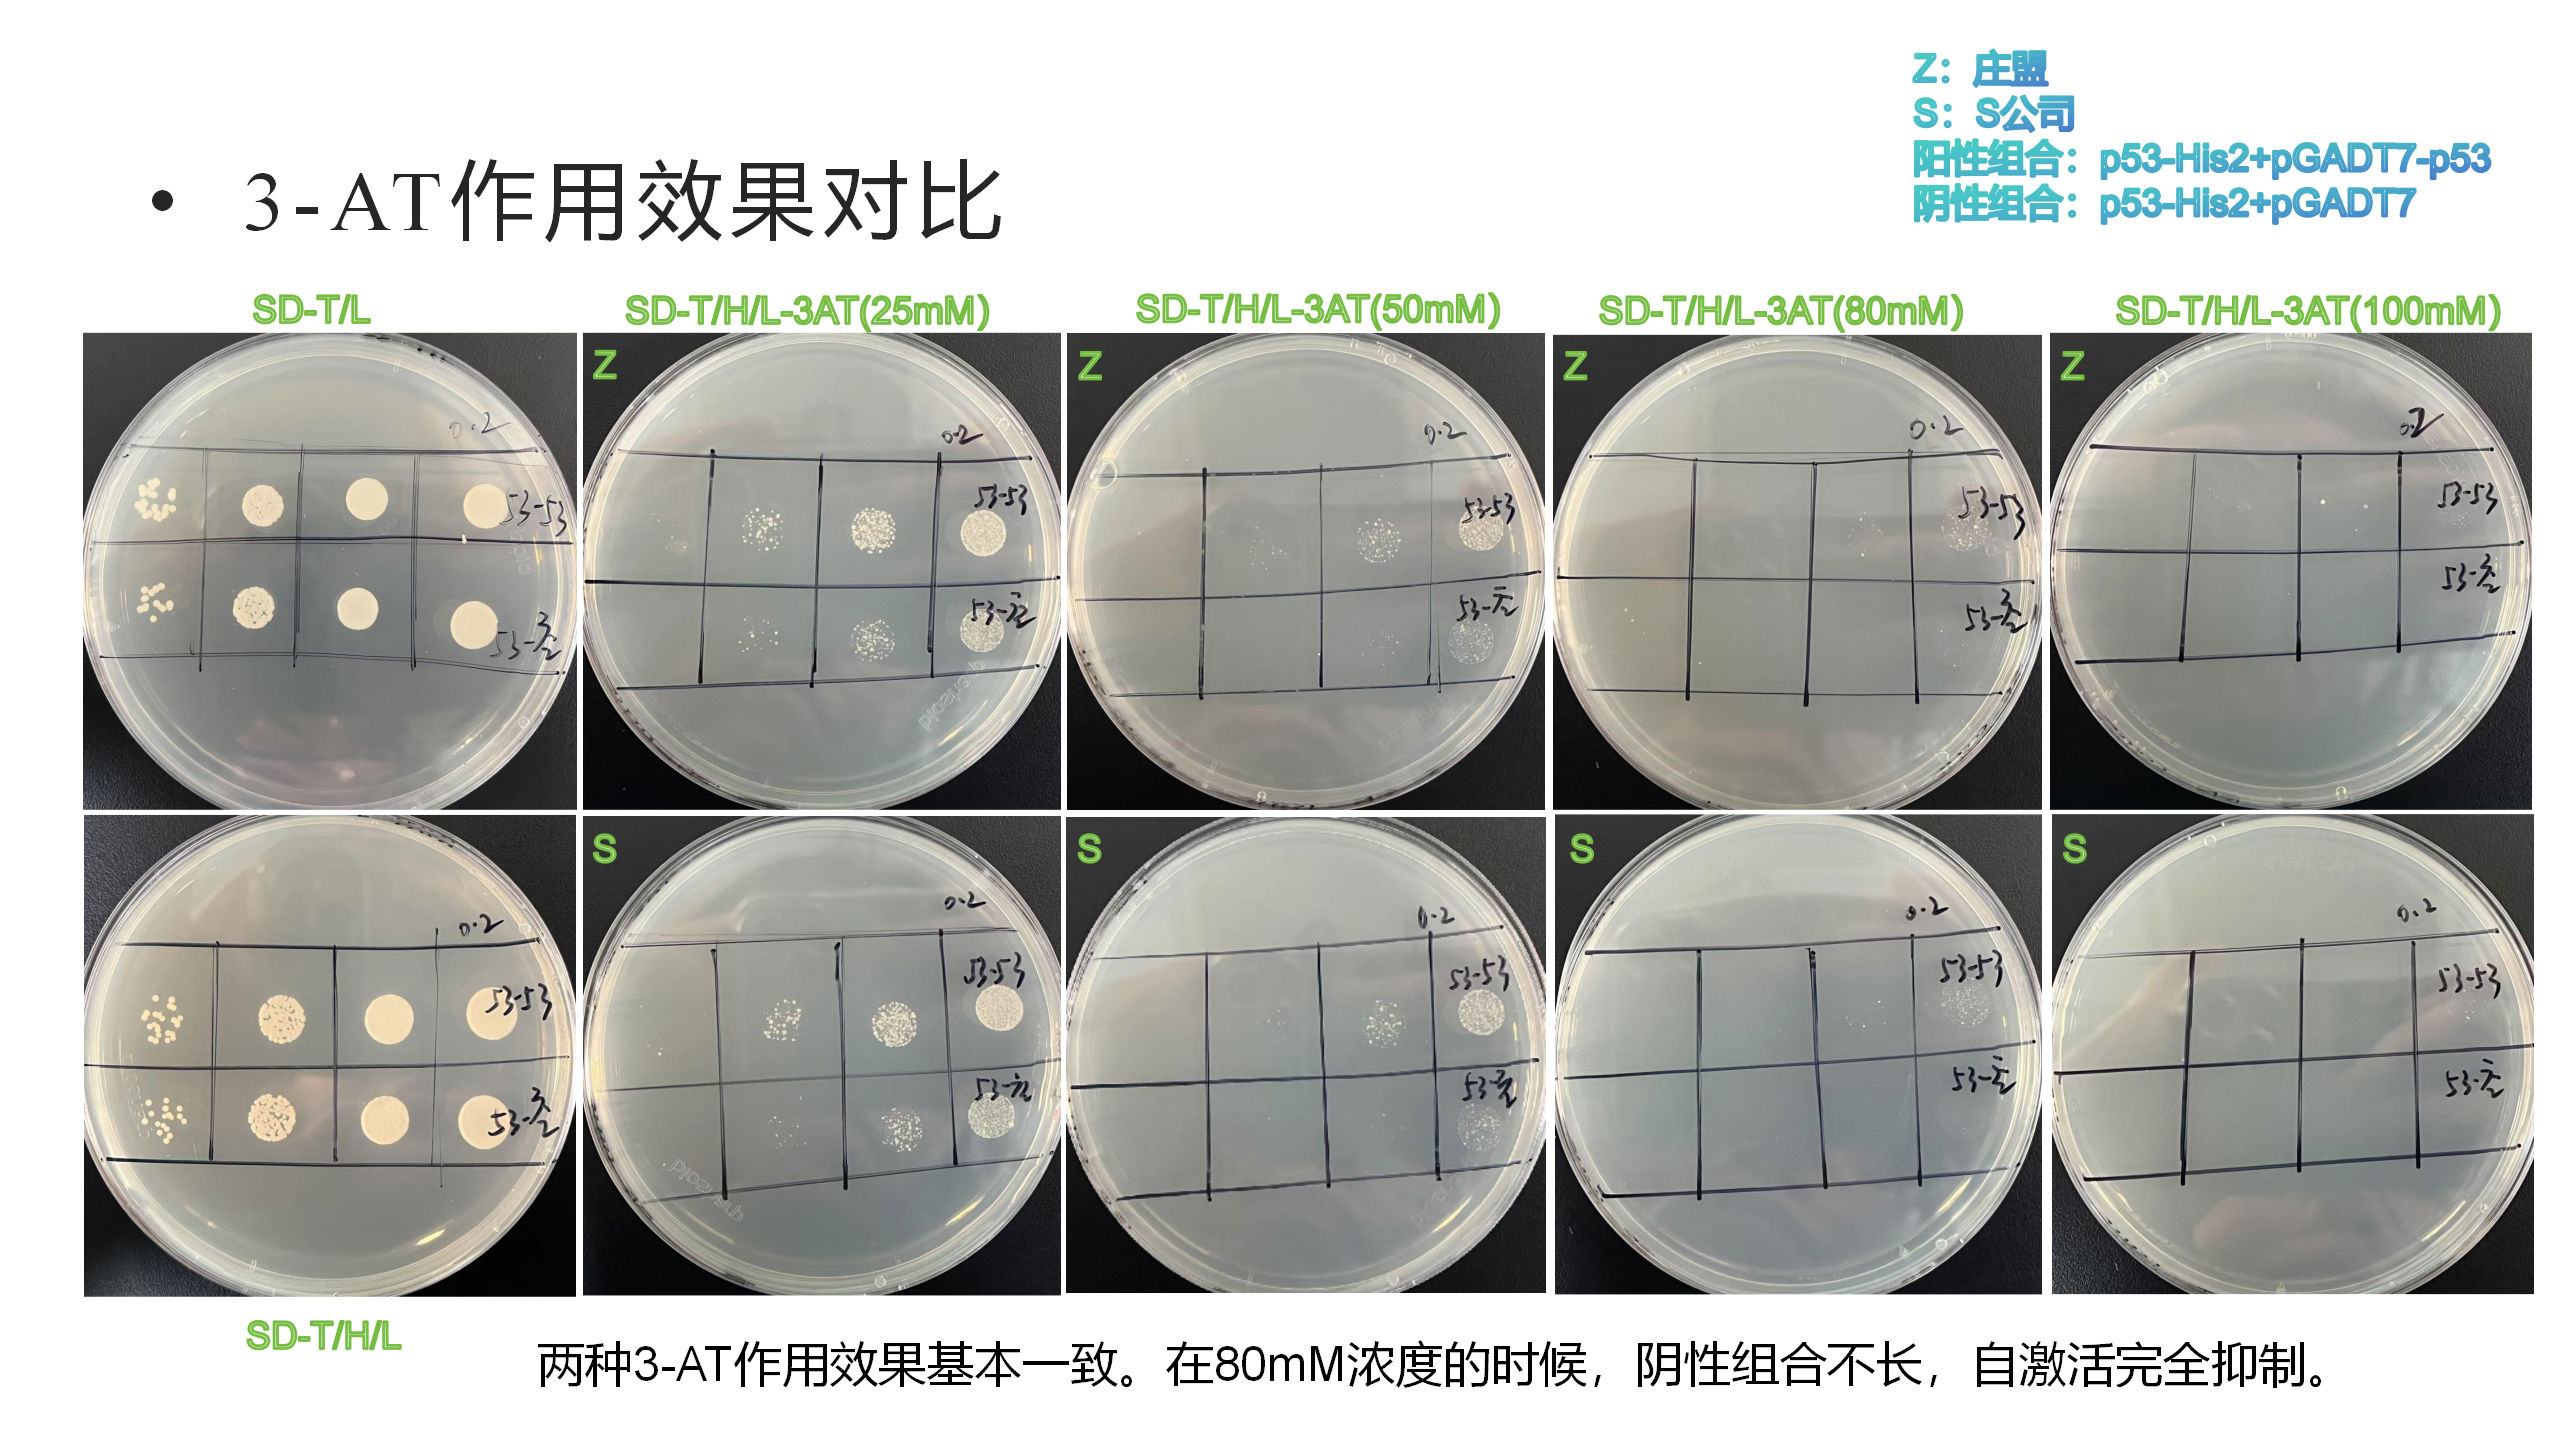

產(chǎn)品簡介:
HIS2作為報告基因時,會有一定程度的泄漏性表達,出現(xiàn)背景過高的現(xiàn)象,一般稱作自激活。這時可以在篩選培養(yǎng)基中加入適量的HIS2競爭性抑制劑3-AT(3-amino-1,2,4-triazole),以降低背景;或者增加一個篩選標(biāo)記Ade來進行更加嚴(yán)格的篩選。加入的3-AT濃度過高,蛋白間比較弱的相互作用也可能被抑制,因此需要篩選確定3-AT的最適濃度。
本公司的3-AT溶液為經(jīng)過過濾除菌的即用型母液,用于酵母雜交實驗抑制本底表達,用以準(zhǔn)確篩選出蛋白互作引發(fā)的His的報告基因的表達。
使用方法:
1.計算所需平板的數(shù)量,計算配置培養(yǎng)基體積;
2.設(shè)置3-AT的濃度梯度(建議10-50 mM 的濃度范圍設(shè)3-5個梯度,常用濃度約30 mM);
3.滅菌篩選培養(yǎng)基,待培養(yǎng)基冷卻到55 ℃左右,加入3-AT母液,搖勻后倒板;
4.標(biāo)記每個平板的3-AT濃度,超凈臺冷卻凝膠后,按單位面積單個克隆計算培養(yǎng)物濃度,涂板;
5.28-30 ℃培養(yǎng)3-5天,篩選出最佳3-AT濃度,用于后期互做篩選。
儲存條件:
1.理想情況10 mM濃度的3-AT平板會有少量生長,20 mM濃度的3-AT不能或極少生長。如果在80 mM濃度的3-AT平板上生長酵母,說明自激活活性太高,不能用于雙雜交篩選。
2.誘餌蛋白能夠單獨激活報告基因的表達,該蛋白如果是具有轉(zhuǎn)錄激活域一個轉(zhuǎn)錄因子,需要去掉轉(zhuǎn)錄激活結(jié)構(gòu)域。如果不是轉(zhuǎn)錄因子但仍具有較強的轉(zhuǎn)錄激活活性,需要將誘餌蛋白具有激活活性的區(qū)域去除,但這樣操作有可能影響蛋白間的互作。
儲存條件:
-20 ℃儲存,有效期24個月。